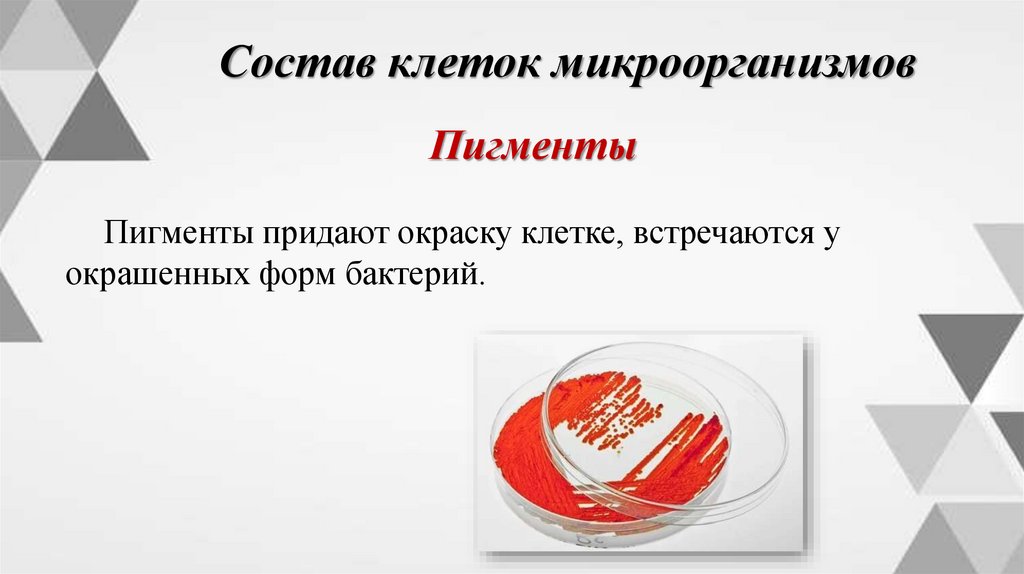

Similar presentations:
Физиология микроорганизмов. Дорожная карта урока
1. Тема урока Физиология микроорганизмов
2.
Физиология микроорганизмовФизиология микроорганизмов – это раздел
микробиологии, изучающий химический состав
микробных клеток, механизмы поступления
питательных веществ внутрь клетки, рост и
размножение.
3.
Дорожная карта урокаПитание
микроорганизмов
Состав клеток
микроорганизмов
Дыхание
микроорганизмов
4.
Состав клеток микроорганизмовХимический состав клетки микроорганизмов на 7585% состоит из воды. Сухой остаток образуют
органические и минеральные вещества.
5.
Состав клеток микроорганизмовВода
В микробной клетке вода может
находиться в двух формах: свободной
и связанной.
6.
Состав клеток микроорганизмовВода
Свободная вода является растворителем питательных
веществ, создает водную фазу для протекания химических
реакций и может сама участвовать в этих реакциях
(гидролиз).
Потеря свободной воды не приводит к гибели клетки,
которая переходит в состояние анабиоза, т.е. остается
жизнеспособной, но не осуществляет жизнедеятельности
(скрытая жизнь).
7.
Состав клеток микроорганизмовВода
Связанная вода прочно связана со структурами клетки,
не является растворителем, не участвует в реакциях, ее
потеря всегда приводит к гибели.
8.
Состав клеток микроорганизмовОрганические вещества
На 95-98% органические вещества состоят из 4
элементов: углерода, кислорода, азота и водорода.
К основным органическим веществам входящим в
состав клетки, относятся белки, нуклеиновые кислоты,
углеводы, липиды (жиры) и пигменты.
9.
Состав клеток микроорганизмовБелки
Белки входят в состав мембран, рибосом и других
элементов клетки.
Белки выполняют каталические функции, являясь
ферментами (белковые соединения, ускоряющие
химические реакции), а также структурными.
Скорость роста клетки зависит от скорости
накопления микроорганизмом белка.
10.
Состав клеток микроорганизмовЛипиды (жиры)
Содержатся в клетках микроорганизмов в небольших
количествах. Они входят в состав цитоплазмы, ядра. Из
них состоят клеточные мембраны.
Жиры также служат энергетическим материалом.
Многие микроорганизмы накапливают жиры в
качестве запасных питательных веществ.
11.
Состав клеток микроорганизмовУглеводы
Углеводы входят в состав капсулы у бактерий, а также
встречаются в виде запасных веществ (крахмал,
гликоген).
Они используются клеткой в качестве
строительного и энергетического материала при
голодании.
12.
Состав клеток микроорганизмовНуклеиновые кислоты
Нуклеиновые кислоты (ДНК и РНК) входят в состав
ядерного вещества, рибосом.
Их главная функция – передача и реализация
наследственной информации.
13.
Состав клеток микроорганизмовПигменты
Пигменты придают окраску клетке, встречаются у
окрашенных форм бактерий.
14.
Состав клеток микроорганизмовМинеральные вещества
Иначе их называют зольными элементами.
Они влияют на осмотическое давление в клетке.
Недостаток одного или нескольких элементов
приводит к замедлению роста или гибели клеток.
15.
Питание микроорганизмовМикробы питаются белками, жирами, углеводами,
минеральными веществами, которые проникают в клетку
в растворенном виде через оболочку путем осмоса.
Осмос – представляет собой диффузию, это когда
вещество пересекает полупроницаемая мембрана чтобы
сбалансировать концентрации другого вещества.
16.
Питание микроорганизмовМикроорганизмы не имеют специальных органов
питания.
Поступление веществ в клетку и выделение продуктов
обмена в окружающую среду происходят у
микроорганизмов через всю поверхность тела.
17.
Питание микроорганизмовПо способу питания микробы делят:
-автотрофы – микроорганизмы, способные
воспринимать углерод из углекислого газа воздуха.
Автотрофы обладают способностью синтезировать
сложные органические соединения из неорганических.
Среди нет болезнетворных микроорганизмов.
18.
Питание микроорганизмов-гетеротрофы (сапрофиты) – используют углерод из
любых готовых органических соединений (углерод
спиртов, сахаров, органических кислот). К
гетеротрофам принадлежат возбудители различных
брожений, гнилостные и болезнетворные
микроорганизмы.
19.
Питание микроорганизмов-паратрофы (паразиты) – паразиты, нуждающиеся в
сложных органических соединениях живых организмов.
20.
Дыхание микроорганизмовДыхание необходимо микроорганизмам для
получения энергии.
В 1861 году французский ученый Л.
Пастер впервые обратил внимание на
уникальную способность микроорганизмов
развиваться без доступа кислорода, в то
время как все высшие организмы – растения
и животные – могут жить только в
атмосфере, содержащей кислород.
21.
Дыхание микроорганизмовПо этому признаку (по типам дыхания) Л. Пастер
разделил микроорганизмы на две группы: аэробы и
анаэробы.
-аэробы – нуждающиеся в кислороде воздуха;
-анаэробы – живущие и развивающиеся при
отсутствии кислорода;
-условные анаэробы – развивающиеся как в
присутствии кислорода, так и без него.
22.
Самостоятельная работаЗаполнить карточку.
Критерии оценивания
«5» – 5
«4» – 4
«3» – 3
«2» – менее 3

biology
biology








